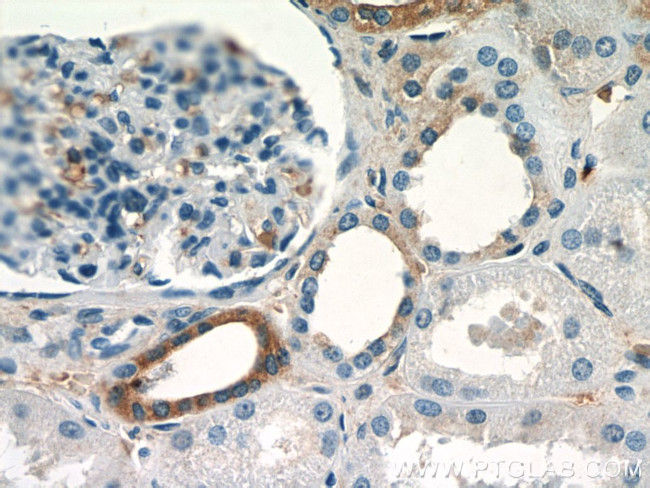
SGLT3/SLC5A4 Antibody in Immunohistochemistry (Paraffin) (IHC (P))

Search
Proteintech
SGLT3/SLC5A4 Polyclonal Antibody
{{$productOrderCtrl.translations['antibody.pdp.commerceCard.promotion.promotions']}}
{{$productOrderCtrl.translations['antibody.pdp.commerceCard.promotion.viewpromo']}}
{{$productOrderCtrl.translations['antibody.pdp.commerceCard.promotion.promocode']}}: {{promo.promoCode}} {{promo.promoTitle}} {{promo.promoDescription}}. {{$productOrderCtrl.translations['antibody.pdp.commerceCard.promotion.learnmore']}}
产品信息
24327-1-AP
种属反应
已发表种属
宿主/亚型
分类
类型
抗原
偶联物
形式
浓度
规格
纯化类型
保存液
内含物
保存条件
运输条件
产品详细信息
Immunogen sequence: SQEETDDGV EEDYPEKSRG CLKKAYDLFC GLQKGPKLTK EEEEALSKKL TDTSER (579-633 aa encoded by BC153069)
靶标信息
Has electrogenic activity in response to glucose, and may function as a glucose sensor (PubMed:13130073, PubMed:17110502, PubMed:20421923, PubMed:22766068). Mediates influx of sodium ions into the cell but does not transport sugars (PubMed:13130073, PubMed:22766068). Also potently activated by imino sugars such as deoxynojirimycin (DNJ) (PubMed:17110502, PubMed:20421923, PubMed:22766068). [UniProt]
仅用于科研。不用于诊断过程。未经明确授权不得转售。
生物信息学
蛋白别名: low affinity sodium-glucose cotransporter; Na(+)/glucose cotransporter 3; Probable glucose sensor protein SLC5A4; SGLT3; sodium transporter; sodium/glucose cotransporter 3; solute carrier family 5 (glucose activated ion channel), member 4; solute carrier family 5 (low affinity glucose cotransporter), member 4; solute carrier family 5 (low affinity glucose cotransporter), member 4a; solute carrier family 5 (neutral amino acid transporters, system A), member 4; Solute carrier family 5 member 4; solute carrier family 5, member 4; solute carrier family 5, member 4a
基因别名: DJ90G24.4; SAAT1; SGLT3; SLC5A4; Slc5a4a
UniProt ID: (Human) Q9NY91, (Rat) D3ZIS0
Entrez Gene ID: (Human) 6527, (Rat) 294341